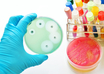
antimicrobial

Minister seeks NIMHANS' help to de-stress police force
PTI | Jan 21, 2019
Swine flu claims five more lives in Rajasthan, toll rises to 48
IANS | Jan 21, 2019
Novel antibiotic to combat drug-resistant hospital superbug
IANS | Jan 21, 2019
Eminent neurologist Jagjit Chopra dies
PTI | Jan 21, 2019
Protein enabling other drugs to increase body's HDL levels identified
IANS | Jan 21, 2019
Chronic doctor shortage affecting Delhi government-run hospitals
IANS | Jan 21, 2019
Anti-inflammatory drugs may put you at heart attack risk
IANS | Jan 21, 2019
Sleeping for long hours during pregnancy linked to stillbirths
IANS | Jan 19, 2019
Extreme distress increases risk for dementia: Study
IANS | Jan 19, 2019
Innovative approach to vision screening to address avoidable blindness
PTI | Jan 19, 2019
Most read this week